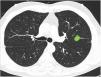

En pacientes con cáncer de pulmón de célula no pequeña (CPCNP) y mediastino normal, en pruebas de imagen, los tumores de localización central presentan mayor afectación mediastínica oculta. Por ello las guías clínicas recomiendan estadificación mediastínica invasiva en esta situación. No obstante, las definiciones de centralidad son poco uniformes entre guías. Desde el área de oncología torácica de la SEPAR se propuso evaluar el grado de familiaridad con varios conceptos relacionados con la localización tumoral entre profesionales que atienden pacientes con CPCNP en nuestro territorio.
MétodosSe envió una encuesta a miembros de sociedades médicas nacionales implicadas en el manejo del CPCNP. La encuesta se estructuró en tres aspectos a evaluar: 1) uniformidad en la definición de localización tumoral central; 2) uniformidad en la clasificación de lesiones que sobrepasan líneas divisorias y 3) capacidad para delimitar lesiones en ausencia de líneas divisorias.
Resultados430 participantes respondieron. La definición de centralidad más votada fue «lesiones en contacto con las estructuras hiliares» (49,7%). Las líneas más escogidas para delimitar el hemitórax fueron líneas concéntricas al hilio (89%). La mayoría (92,8%) consideró los tumores según en qué lado de la línea divisoria se encontrase la mayor parte de su volumen. Un 78,6% fue capaz de catalogar correctamente una lesión central en ausencia de líneas divisorias.
ConclusionesEn nuestra encuesta, la definición de centralidad más aceptada no es ninguna de las propuestas en las guías clínicas. Los resultados reflejan amplia variabilidad para clasificar lesiones tumorales.
In patients with non-small cell lung cancer (NSCLC) and normal mediastinal imaging tests, centrally located tumors have greater occult mediastinal involvement. Clinical guidelines, therefore, recommend invasive mediastinal staging in this situation. However, definitions of centrality in the different guidelines are inconsistent. The SEPAR Thoracic Oncology area aimed to evaluate the degree of familiarity with various concepts related to tumor site among professionals who see patients with NSCLC in Spain.
MethodsA questionnaire was distributed to members of Spanish medical societies involved in the management of NSCLC, structured according to the 3 aspects to be evaluated: 1) uniformity in the definition of central tumor location; 2) uniformity in the classification of lesions that extend beyond dividing lines; and 3) ability to delineate lesions in the absence of dividing lines.
ResultsA total of 430 participants responded. The most voted definition of centrality was «lesions in contact with hilar structures» (49.7%). The lines most often chosen to delimit the hemitorax were concentric hilar lines (89%). Most participants (92.8%) classified tumors according to the side of the dividing line that contained most of their volume. Overall, 78.6% were able to correctly classify a central lesion in the absence of dividing lines.
ConclusionsIn our survey, the most widely accepted definition of centrality is not one of the proposals specified in the clinical guidelines. The results reflect wide variability in the classification of tumor lesions.
En pacientes con carcinoma pulmonar de célula no pequeña (CPCNP) la estadificación mediastínica es fundamental, tanto como factor pronóstico como para una óptima elección del tratamiento. El estudio inicial del mediastino se basa en la tomografía computarizada (TC) y la tomografía por emisión de positrones (PET), tanto por separado como en combinación (PET/TC). No obstante, las técnicas de imagen presentan limitaciones diagnósticas y en algunos casos un resultado negativo puede ocultar enfermedad ganglionar mediastínica. Más concretamente, tres situaciones clínicas se han relacionado con una elevada tasa de falsos negativos de la PET: tumores de más de 3 cm de diámetro, afectación N1 en pruebas de imagen y tumores de localización central. Por este motivo, las guías clínicas basadas en la evidencia para la estadificación mediastínica prequirúgica del CPCNP propuestas por la European Society of Thoracic Surgeons (ESTS)1, por el American College of Chest Physicians (ACCP)2 y por la Sociedad Española de Neumología y Cirugía Torácica (SEPAR)3 recomiendan estadificación mediastínica invasiva no solo en pacientes con mediastino patológico en CT y/o PET sino, además, en aquellos con mediastino normal en alguna de estas tres situaciones clínicas descritas. Mientras que la medición de tumores mayores a 3 cm puede ser objetiva y relativamente fácil de realizar, la determinación de localización central del tumor es muy controvertida ya que no existe una definición uniforme de localización tumoral central. La ESTS se refiere a «los tumores situados en los 2/3 internos del pulmón», mientras que la ACCP a «los tumores situados en el 1/3 interno del hemitórax» y la SEPAR a «tumores de localización central habitualmente en contacto con el mediastino». Asimismo, otras definiciones de localización central, descritas en estudios científicos (como la de Gómez-Caro et al.)4 o en guías de otras sociedades (por ejemplo, como criterio de exclusión para radioterapia esterotáctica)5 han aumentado la confusión al respecto. Esta falta de uniformidad conlleva a una amplia variabilidad en la práctica clínica de los profesionales responsables del manejo de pacientes con CPCNP. En este sentido, recientemente se realizó en Estados Unidos una encuesta a 218 cirujanos torácicos y neumólogos6. Los resultados de la misma demostraron una amplia diversidad de criterio a la hora de definir las lesiones centrales entre profesionales responsables de la atención de pacientes con CPCNP. En vista de esta falta de criterio uniforme en la literatura y entre sociedades, desde el área de Oncología Torácica de la SEPAR se planteó la necesidad de realizar un estudio transversal para valorar la situación dentro de nuestro territorio. Así pues, el objetivo de nuestro estudio fue evaluar el grado de familiaridad con varios conceptos relacionados con la localización tumoral central entre profesionales médicos que atienden a pacientes con CPCNP en nuestro país. Más concretamente, se pretendieron evaluar: 1) la uniformidad de criterio en la definición de localización tumoral central; 2) la uniformidad a la hora de clasificar lesiones que sobrepasan líneas divisorias y 3) la capacidad de delimitar lesiones en ausencia de líneas divisorias.
MétodosUn cuestionario de acceso libre compuesto por preguntas con respuesta de opción múltiple, con o sin imágenes de TC torácico, fue enviado por correo electrónico a todos los miembros del área de Oncología Torácica de la Sociedad Española de Neumología y Cirugía Torácica (SEPAR), la Sociedad Española de Cirugía Torácica (SECT), el Grupo Español de Cáncer de Pulmón (GECP) y la Sociedad Española de Imagen Cardiotorácica (SEICAT).
CuestionarioLa encuesta fue abierta el 4 de junio y se cerró el 15 de septiembre de 2019. El cuestionario se estructuró en tres bloques:
- 1)
Definición de centralidad (fig. 1): en este bloque se valoró la uniformidad de criterio para definir centralidad.
Figura 1.En este bloque se valoró la uniformidad de criterio para definir centralidad. Imagen 1: ¿Considera que el nódulo tiene localización? Central/Periférica. Imagen 2: ¿Considera que el nódulo tiene localización? Central/Periférica. Imágenes 3a y 3b ¿Considera que el nódulo tiene localización? Central/Periférica. Imagen 4: ¿Cuál de las siguientes líneas define mejor centralidad? Líneas A/Líneas B. Imagen 5: ¿Cuál de las siguientes líneas define mejor centralidad? Líneas A/Líneas B. Imagen 6: ¿Cuál de las dos líneas delimita un tumor central? Línea A (1/3 central)/Línea B (2/3 centrales). Imagen 7: ¿Cuál de las dos líneas delimita un tumor central? Línea A (1/3 central)/Línea B (2/3 centrales). Imagen 8: ¿Considera que el nódulo tiene localización? Central/Periférica. Imagen 9: ¿Considera que el nódulo tiene localización? Central/Periférica.
- 2)
Clasificación de lesiones que sobrepasan líneas divisorias (fig. 2): en este bloque se valoró la uniformidad de criterio para clasificar una lesión como central (según una definición de centralidad (en los 2/3 internos) previamente establecida en el enunciado de la pregunta) en lesiones que sobrepasan las líneas divisorias, previamente trazadas en la imagen.
Figura 2.En este bloque se valoró la uniformidad de criterio para clasificar una lesión como central en lesiones que sobrepasan las líneas divisorias. Imagen 10: Considerando que la localización en los 2/3 internos del hemitórax corresponde con centralidad ¿Diría que el nódulo tiene localización? Central/Periférica. Imagen 11: Considerando que la localización en los 2/3 internos del hemitórax corresponde con centralidad ¿Diría que el nódulo tiene localización? Central/Periférica.
- 3)
Capacidad para correctamente clasificar una lesión entre central y periférica en ausencia de líneas divisorias (fig. 3): en este bloque se valoró la capacidad de clasificar correctamente una lesión central (según una definición de centralidad [en los 2/3 internos] previamente establecida en el enunciado de la pregunta) en ausencia de líneas divisorias.
Los resultados de la encuesta se recogieron en una base de datos y se analizaron utilizando el programa Stata S/E (StataCorp. 2014. Stata Statistical Software: Release 13. College Station, TX: StataCorp LLC). Las variables categóricas se expresaron como frecuencias absolutas y relativas y las variables continúas como media (m) y desviación standard (DE) en caso de distribución normal y como mediana (M) y rango intercuartílico (RIC) (25%-75%) en caso de distribución no normal. Las respuestas al cuestionario se compararon entre diferentes especialidades utilizando el test exacto de Fisher. Asimismo, se compararon las respuestas a diferentes preguntas utilizando el test exacto de Fisher. Se consideró un resultado estadísticamente significativo si la p obtenía un resultado < 0,05.
ResultadosUn total de 430 encuestados respondieron el cuestionario. La mayoría de los participantes tenían entre 30-45 años (45,9%), eran neumólogos (53,5%) y tenían participación directa en el diagnóstico de cáncer de pulmón (86,5%).
Definición de centralidadCasi la mitad de los participantes escogieron «lesiones en contacto con las estructuras hiliares» (49,7%) como definición de localización tumoral central (tabla 1 [pregunta 1]). Las líneas más elegidas para delimitar centralidad fueron líneas B (líneas concéntricas al hilio pulmonar) (89%) (imágenes 4 y 5). La imagen «control positivo lesión periférica» (imagen 1) fue catalogada como periférica por la totalidad de los participantes mientras que la imagen «control positivo lesión central» (imagen 2) fue catalogada como central por tres cuartas partes de los participantes. La imagen escogida como «control positivo lesión central SEPAR» (imágenes 3a y 3b) fue mayormente catalogada como periférica (71,1%). La mayoría de los participantes votaron por delimitar la centralidad en el 1/3 interno del hemitórax, en lugar de los 2/3 internos tanto para las líneas A (imagen 6) (310 [72,3%]) como para las líneas B (imagen 7) (339 [79%]). La presencia de lesión endobronquial influyó en la consideración de una lesión como central ya que la misma imagen pasó de ser catalogada central por solo un 7% de los participantes (imagen 8) a un 36,1% (imagen 9) al añadir la información de una imagen endobronquial (test exacto de Fisher p< 0,01). Al contrario de otras preguntas, en esta imagen sí se observaron diferencias estadísticamente significativas entre especialidades (test exacto de Fisher p< 0,01) (tabla 1).
Uniformidad definiciones de centralidad
| Total(N=429)Número (%) | Neumólogo(N=230)Número (%) | Cirujano Torácico (N=82)Número (%) | Oncólogo(N=30)Número (%) | Radiólogo(N=76)Número (%) | Otra(N=11)Número (%) | P | |||
|---|---|---|---|---|---|---|---|---|---|
| Imagen 11: | Pregunta: ¿Considera que la lesión tiene localización? | Central | 0 | 0 | 0 | 0 | 0 | 0 | |
| Periférica | 429 (100) | 230 (100) | 82 (100) | 30 (100) | 76 (100) | 11 (100) | |||
| NS/NC | 0 | 0 | 0 | 0 | 0 | 0 | |||
| Imagen 22: | Pregunta: ¿Considera que la lesión tiene localización? | Central | 325 (75.8) | 188 (81.7) | 49 (59.7) | 24 (80) | 53 (69.7) | 11 (100) | <0.01a |
| Periférica | 104 (24.2) | 42 (18.3) | 33 (40.3) | 6 (20) | 23 (30.3) | 0 | |||
| NS/NC | 0 | 0 | 0 | 0 | 0 | 0 | |||
| Imagen 33: | Pregunta: ¿Considera que la lesión tiene localización? | Central | 123 (28.7) | 75 (32.6) | 14 (17.1) | 17 (56.7) | 14 (18.4) | 3 (27.3) | <0.01a |
| Periférica | 305 (71.1) | 154 (70) | 68 (82.9) | 13 (43.3) | 62 (81.6) | 8 (72.7) | |||
| NS/NC | 1 (0.2) | 1 (0.4) | 0 | 0 | 0 | 0 | |||
| Imagen 44: | Pregunta:¿Cuál de las siguientes líneas define mejor Centralidad? | Líneas A | 47 (11) | 23 (10) | 9 (11) | 3 (10) | 11 (14.5) | 1 (9.1) | P=0.82 |
| Líneas B | 382 (89) | 207 (90) | 73 (89) | 27 (90) | 65 (85.5) | 10 (90.9) | |||
| NS/NC | 0 | 0 | 0 | 0 | 0 | 0 | |||
| Imagen 55: | Pregunta: ¿Cuál de las siguientes líneas define mejor Centralidad? | Líneas A | 39 (9.1) | 19 (8.3) | 6 (7.3) | 4 (13.3) | 9 (11.8) | 1 (9.1) | P=0.82 |
| Líneas B | 389 (90.7) | 210 (91.3) | 76 (92.7) | 26 (86.7) | 67 (88.2) | 10 (90.9) | |||
| NS/NC | 1 (0.2) | 1 (0.4) | 0 | 0 | 0 | 0 | |||
| Imagen 66: | Pregunta: ¿Cuál de las dos líneas delimita un tumor central? | 1/3 central | 310 (72.3)b | 172 (74.8) | 53 (64.6) | 18 (60) | 58 (76.3) | 9 (81.8) | p<0.03a |
| 2/3 centrales | 76 (17.7) | 45 (19.6) | 15 (18.3) | 5 (16.7) | 10 (13.2) | 1 (9.1) | |||
| NS/NC | 43 (10) | 13 (5.6) | 14 (17.1) | 7 (23.3) | 8 (10.5) | 1 (9.1) | |||
| Imagen 77: | Pregunta: ¿Cuál de las dos líneas delimita un tumor central? | 1/3 central | 339 (79)b | 173 (75.2) | 66 (80.5) | 25 (83.3) | 66 (86.8) | 9 (81.8) | P=0.56 |
| 2/3 centrales | 88 (20.6) | 56 (24.4) | 15 (18.3) | 5 (16.7) | 10 (13.2) | 2 (18.2) | |||
| NS/NC | 2 (0.4) | 1 (0.4) | 1 (1.2) | 0 | 0 | 0 | |||
| Imagen 88: | Pregunta: ¿Considera que la lesión tiene localización? | Central | 30 (7) | 16 (7) | 8 (9.7) | 1 (3.4) | 3 (3.9) | 2 (18.2) | <0.05a |
| Periférica | 398 (92.8) | 214 (93) | 74 (90.3) | 29 (96.7) | 73 (96.1) | 8 (72.7) | |||
| NS/NC | 1 (0.2) | 0 | 0 | 0 | 0 | 1 (9.1) | |||
| Imagen 99: | Pregunta: ¿Considera que la lesión tiene localización? | Central | 155 (36.1)c | 104 (45.2)c | 30 (36.6) | 4 (13.3) | 14 (18.4)c | 3 (27.2) | P=0.49 |
| Periférica | 270 (63) | 126 (54.8) | 50 (61) | 26 (86.7) | 60 (79) | 8 (72.8) | |||
| NS/NC | 4 (0.9) | 0 | 2 (2.4) | 0 | 2 (2.6) | 0 | |||
| Pregunta 1:¿Qué definición utiliza usted para clasificar una lesión como central? | Lesiones con contacto hiliar | 213 (49.7) | 99 (43) | 55 (67) | 17 (56.7) | 37 (48.7) | 5 (45.4) | <0.03a | |
| Lesiones en 1/3 central | 51 (11.9) | 25 (10.9) | 8 (9.8) | 3 (10) | 13 (17.1) | 2 (18.2) | |||
| Lesiones en 2/3 centrales | 143 (33.3) | 89 (38.7) | 18 (22) | 8 (26.7) | 25 (32.9) | 3 (27.3) | |||
| Lesiones en contacto con el mediastino | 3 (0.7) | 2 (0.9) | 0 | 1 (3.3) | 0 | 0 | |||
| Lesiones endobronquiales | 11 (2.6) | 11 (4.8) | 0 | 0 | 0 | 0 | |||
| Otra | 7 (1.6) | 4 (1.7) | 1 (1.2) | 1 (3.3) | 0 | 1 (9.1) | |||
| NS/NC | 1 (0.2) | 0 | 0 | 0 | 1 (1.3) | 0 | |||
Test exacto de Fisher p<0.01.
1La imagen del nódulo corresponde a una lesión periférica (“control positivo lesión periférica”) tanto según la definición de la ESTS como de la ACCP, con independencia de las líneas divisorias a utilizar (líneas paralelas a la línea media [líneas A] o líneas concéntricas al hilio [líneas B])
2 La imagen del nódulo corresponde a una lesión central (“control positivo lesión central”) tanto según la definición de la ESTS como de la ACCP, con independencia de las líneas divisorias a utilizar (líneas A o líneas B)
3 La imagen del nódulo corresponde a una lesión central según la definición de localización tumoral central de la SEPAR (“control central SEPAR”)
4En la imagen aparecen líneas A y líneas B en un corte coronal de TC
5En la imagen aparecen líneas A y líneas B en un corte axial de TC
6En la imagen aparecen líneas A en un corte axial de TC y los encuestados deben escoger entre 1/3 interno y 2/3 internos como límite divisorio para clasificar lesiones
7En la imagen aparecen líneas B en un corte axial de TC y los encuestados deben escoger entre 1/3 interno y 2/3 internos como límite divisorio para clasificar lesiones
8La imagen del nódulo corresponde a una lesión periférica (“control positivo lesión periférica”) tanto según la definición de la ESTS como de la ACCP, con independencia de las líneas divisorias a utilizar (líneas A o líneas B)
9Se trata de la misma imagen que la imagen 8 incluyendo una imagen de lesión endobronquial de una broncoscopia flexible
La mayoría de los participantes en la encuesta consideraron las lesiones según la mayor parte de su volumen se encontrase a un lado u otro de una línea divisoria previamente trazada en la imagen. Así pues, las lesiones predominantemente situadas en el lado periférico se catalogaron como periféricas (imagen 10) (92,8%) y las predominantemente situadas en el lado central, como centrales (imagen 11) (79,2%) sin apreciarse diferencias entre especialidades (tabla 2).
Categorización de lesiones que atraviesan líneas divisorias (con la mayor parte en la zona periférica Vs con la mayor parte en la zona central). La mayoría de los encuestados consideran que las lesiones se deben considerar según la mayor parte de su volumen se encuentre en un lugar u otro determinado. No se observan diferencias significativas entre grupos de especialidades diferentes ni para la primera pregunta ni para la segunda (aTest exacto de Fisher)
| Total(N=429) | Neumólogos(230) | Cirujanos torácicos (82) | Oncólogos (30) | Radiólogos (76) | Otros (11) | P | |||
|---|---|---|---|---|---|---|---|---|---|
| Imagen 10: Lesión que atraviesa las líneas divisorias (mayor parte de volumen en situación periférica) | Pregunta: ¿Diría que el nódulo tiene localización? | Central | 28 (6.5) | 14 (6.1) | 8 (9.8) | 1 (3.3) | 4 (5.3) | 1 (9.1) | p=0.49a |
| Periférico | 398 (92.8) | 215 (93.5) | 74 (90.2) | 29 (96.7) | 70 (92.1) | 10 (90.9) | |||
| NS/NC | 3 (0.7) | 1 (0.4) | 0 | 0 | 2 (2.6) | 0 | |||
| Imagen 11: Lesión que atraviesa las líneas divisorias (mayor parte de volumen en situación central) | Pregunta: ¿Diría que el nódulo tiene localización? | Central | 340 (79.2) | 181 (78.7) | 72 (87.8) | 21 (70) | 60 (78.9) | 6 (54.6) | P=0.12a |
| Periférico | 87 (20.3) | 47 (20.4) | 10 (12.2) | 9 (30) | 16 (21.1) | 5 (45.4) | |||
| NS/NC | 2 (0.5) | 2 (0.9) | 0 | 0 | 0 | 0 | |||
La mayoría de los participantes (78,6%) fueron capaces de catalogar una lesión central en ausencia de líneas divisorias (imagen 12), sin diferencias significativas entre especialidades (tabla 3). Del mismo modo, la edad, sexo o participación directa en el manejo de pacientes con cáncer de pulmón no influyeron en la respuesta a ninguna de las preguntas.
Capacidad de identificar correctamente un nódulo central en ausencia de líneas divisorias (imagen 12). La mayoría de los profesionales son capaces de identificar correctamente una lesión central (casillas en verde) en ausencia de las líneas divisorias sin que se observen diferencias significativas entre grupos
aTest exacto de Fisher P = 0,18.
Nuestra encuesta, realizada entre más de 400 profesionales implicados en el diagnóstico y tratamiento del carcinoma de pulmón de nuestro país, muestra que la definición de centralidad más aceptada por los participantes no es ninguna de las propuestas en las guías clínicas. Asimismo los resultados reflejan una importante falta de uniformidad a la hora de clasificar lesiones tumorales centrales, aunque sí se observan unos patrones de respuesta mayoritarios entre los participantes: las líneas divisorias preferidas son las líneas concéntricas radiales al hilio (líneas B), el límite más aceptado como central es el 1/3 interno y en la mayoría de los casos se acepta que una lesión que atraviesa una línea divisoria debe ser clasificada según donde se encuentre la mayoría de su volumen. Igualmente llama la atención que, a pesar del carácter subjetivo de las definiciones actuales, la mayoría de los participantes en la encuesta fueron capaces de delimitar correctamente una lesión central en ausencia de líneas divisorias.
El concepto de localización tumoral central fue introducido por Daly et al.7 en 1987. Estos autores describieron que los tumores de localización central, que definieron como aquellas lesiones que eran visualizadas en la broncoscopia flexible o que se localizaban en el tercio central del pulmón en la proyección anteroposterior de la radiografía de tórax, tenían mayor probabilidad de afectación ganglionar mediastínica oculta en la TC torácica. En los años 90, con la introducción de los primeros equipos PET, que disponían de baja resolución de imagen, se aceptó que los tumores de localización central podían ocultar adenopatías mediastínicas en su vecindad. Este fenómeno se conoció como el hot-spot effect. En este siglo, además de incrementarse la evidencia a favor de que la localización tumoral central se asociaba a mayor tasa de falsos negativos en las pruebas de imagen, aparecieron nuevas definiciones de localización tumoral central como la propuesta por Gómez-Caro et al.4 (lesiones en contacto con las estructuras hiliares [bronquios lobares, arterias pulmonares principales o lobares, venas pulmonares principales]) o la introducida por la American Association of Radiation Oncology5 (lesiones situados a una distancia menor de 2 cm del árbol bronquial). Si bien esta última se describió para la detección de pacientes con riesgo de toxicidad por radioterapia esterotáctica y no con fines de estadificación mediastínica, estas nuevas definiciones incrementaron la confusión en cuanto a la definición de localización tumoral central. Más recientemente aparecieron las guías de estadificación mediastínica basadas en la evidencia de la SEPAR, ACCP y ESTS con diferencias notables entre ellas en cuanto a la definición de localización tumoral central. En nuestro estudio, a la pregunta «¿Qué definición utiliza usted para clasificar una lesión como central?» (pregunta 1) ninguna de las definiciones propuestas por las guías fue la más votada. La definición más aceptada fue la propuesta por Gómez-Caro4 (lesiones en contacto hiliar) con casi la mitad de los votos, seguida por la definición de la ESTS (lesiones en los dos tercios centrales) y la de la ACCP (lesiones en el tercio central). De forma contradictoria con este resultado, en la comparación directa entre las definiciones de la ESTS y la ACCP (imágenes 6 y 7), la mayoría de los participantes se decantaron por la última al delimitar la centralidad en el tercio interno del hemitórax. La definición propuesta por la SEPAR apenas fue votada en la pregunta 1 y la imagen de «control positivo lesión central SEPAR» fue mayoritariamente catalogada como periférica. Estos resultados denotan una importante desviación de la población participante respecto a las guías clínicas.
Además de la falta de uniformidad, las guías clínicas son muy breves al definir localización tumoral central. Esta brevedad lleva a que actualmente no se encuentren respuestas a preguntas que surgen de la práctica clínica habitual como ¿Qué porción del tumor debe considerarse para su clasificación (borde interno, borde externo, centro)? ¿Qué líneas deben utilizarse para delimitar los tercios pulmonares? ¿Cómo deben clasificarse los tumores que sobrepasan las líneas divisorias? En cuanto a la segunda pregunta, históricamente, siguiendo la definición de Daly et al.7, se han utilizado líneas divisorias verticales paralelas a la línea media (líneas A). No obstante, en 2007 otros autores describieron líneas curvas concéntricas al hilio (líneas B)8 y más recientemente Shin et al.9 han descrito líneas curvas concéntricas a la línea media. En nuestra encuesta, las líneas más aceptadas para delimitar los tercios fueron las líneas B, lo cual está en consonancia con la definición más aceptada de localización tumoral central (en contacto con estructuras hiliares) y demuestra que la mayoría de los participantes relaciona la localización central con el hilio pulmonar en lugar de con la línea media. En cuanto a las lesiones que atraviesan las líneas divisorias, en lugar de considerarlas a todas como centrales, la mayoría de participantes las clasificó según se encontrara la mayor parte de su volumen.
Recientemente el papel de la localización tumoral central como predictora de enfermedad mediastínica se encuentra en entredicho debido a la aparición de estudios que muestran resultados contradictorios4,8,10-15. Algunos autores afirman que esta disparidad puede ser debida al uso de diferentes definiciones para localización tumoral central en cada uno de los estudios16. Por este motivo, en los últimos dos años se han publicado tres estudios que utilizaban varias definiciones de localización central9,17,18. El resultado ha sido que ninguna de las definiciones propuestas en las guías se asociaba a enfermedad ganglionar mediastínica oculta en ninguna de las tres series. Otro aspecto a tener en cuenta es que, debido a que los tumores mayores a 3 cm y los tumores N1 en pruebas de imagen se asocian por sí mismos a enfermedad ganglionar mediastínica oculta, con cifras de enfermedad N2 en torno a 11 y 26%, respectivamente19,20; la localización central como indicación de estadificación mediastínica invasiva afecta únicamente a los nódulos pulmonares (T1N0 en pruebas de imagen). En este sentido, únicamente tres estudios han incluido población exclusivamente compuesta por pacientes con tumores T1N0 en pruebas de imagen18,21,22. En las tres series la prevalencia de enfermedad ganglionar mediastínica oculta fue baja (entre 4,7 y 8%) y no se encontró relación entre ésta y la localización tumoral. Así pues, actualmente el papel de la localización tumoral central en la estadificación mediastínica es un tema controvertido, en primer lugar, por la falta de uniformidad en la definición y, en segundo, por las dudas en cuanto a su asociación con enfermedad mediastínica oculta en la población de pacientes con tumores T1N0 en pruebas de imagen.
Nuestros resultados, a pesar de incluir una población notablemente superior a estudios similares6, tienen que ser interpretados con la cautela de toda encuesta y no considerarse representativos de toda la población médica que atiende a pacientes con cáncer de pulmón en nuestro país. No obstante, consideramos que la falta de una definición uniforme de centralidad y la discrepancia con las guías clínicas es muy llamativa y merecen una reflexión.
ConclusionesEn resumen, el presente estudio demuestra una falta de uniformidad en cuanto a la definición de localización tumoral central entre profesionales responsables del manejo de pacientes con CPCNP que han participado en la encuesta. Asimismo, muestra una baja adecuación de los participantes de la encuesta a las guías clínicas en cuanto a ciertos aspectos de la localización central, fundamentalmente en cuanto a la referencia espacial de centralidad, que las guías establecen en la línea media y la mayoría de los participantes en la encuesta en el hilio. A pesar de las limitaciones del estudio, los resultados del mismo nos reflejan la necesidad de incluir una definición más uniforme y amplia de localización tumoral central en las próximas guías clínicas en caso de que este criterio siga manteniéndose como indicación de estadificación mediastínica invasiva.
Conflicto de interesesLos autores declaran no tener ningún conflicto de intereses.